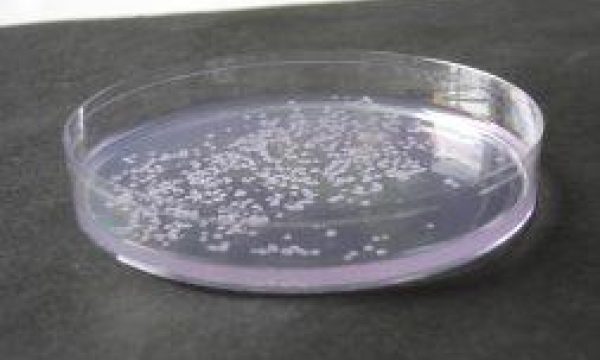

Bacterial growth on medium
 Diagnostic Centre for Plants
Diagnostic Centre for Plants
Bacterial growth on medium

Red mite

Meloidogyne chitwoodi

Fungi on strawberry

Orchid (Odontoglossum ringspot virus)